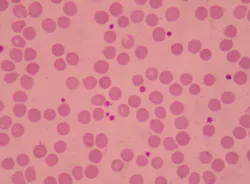
65785dd314596a001e2d785c Dreamstime Xxl 120466771 1 65785dd314596a001e2d785c Dreamstime Xxl 120466771 1

Registration is open for AABB’s upcoming Hot Topic Discussion with the Food and Drug Administration on cold-stored platelets. The program will take place 12-1 p.m. ET on Thursday, Dec. 14. Registration is complimentary for AABB members.
In this program, representatives from FDA will answer questions and discuss considerations and concerns related to cold-stored platelets and the agency’s June 2023 guidance, “Alternative Procedures for the Manufacture of Cold-Stored Platelets Intended for the Treatment of Active Bleeding when Conventional Platelets Are Not Available or Their Use Is Not Practical.” The program will also focus on the regulatory history and rationale for cold-stored platelet components and describe the available evidence for their use in the treatment of active bleeding.